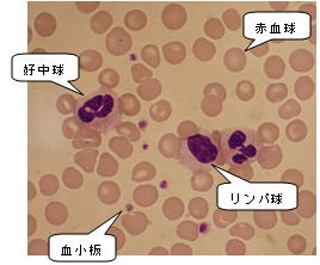
血液像（白血球分画）検査
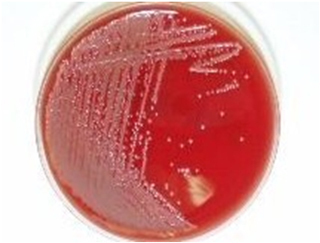
support-p40-001.jpg

中央検査技術科
国際規格ISO15189認定を取得しました。(2023年3月3日)
業務内容 生化学・免疫検査室 血液検査室 一般検査室 輸血検査室 細菌検査室 病理検査室 生理機能検査室 学会・論文発表
業務内容
スタッフ構成
臨床検査技師29名(うち、認定輸血検査技師1名、超音波検査士1名、認定心電検査技師3名、緊急臨床検査士9名、二級臨床検査士<血液3名、病理1名、臨床化学1名、免疫血清1名、微生物1名>、認定病理検査技師3名、細胞検査士4名、国際細胞検査士3名、特定化学物質作業主任者2名、有機溶剤作業主任者4名)、看護師3名、事務員2名、総勢34名により構成されています。
(2025年6月現在)
臨床検査とは
臨床検査は病気の原因を調べたり、治療の効果をみるために行われ、大きく検体検査と生理機能検査の2種類に分類されます。
(検体検査)
身体から血液・尿・組織などを採取して、その中の成分や細胞形態を調べる検査で、当院の検査科では6つの部門に分かれています。
| (1)生化学・免疫検査 | 最新の自動分析器を用いて、血液に含まれる肝機能成分や腎機能成分、腫瘍マーカーの測定、肝炎などのウイルス検査などを行っています。 |
|---|---|
| (2)血液検査 | 赤血球・白血球などの血球数の測定、凝固機能検査、血球形態検査などを行っています。 |
| (3)一般検査 | 尿の成分分析や細胞分類、便の潜血検査や虫卵検査を行っています。 |
| (4)輸血検査 | 輸血時の交差適合試験、不規則抗体の検出、血液製剤の発注/保管管理を行っています。 |
| (5)細菌検査 | 一般細菌・結核菌・真菌の培養や同定、抗生物質感受性試験を行っています。 |
| (6)病理・細胞診検査 | 病理検査では、生検材料や手術材料から組織標本を作製し、病理医が鏡検・診断を行っています。 細胞検査では、喀痰・尿・体腔液・産婦人科の擦過材料などから作製した標本を細胞検査士が鏡検しています。異常細胞や確認すべき所見があった標本は病理医と検討し、報告しています。 |
(生理機能検査)
患者さんに直接電極などを取り付け、生体情報を取り出す検査です。心電図、呼吸機能、脳波、心臓・腹部超音波、聴力・平衡機能検査などを行っています。
おもな血液・尿検査結果の簡単な見方
『おもな血液・尿検査結果の簡単な見方』のパンフレットを作成し、中央検査技術科待合廊下に掲示しています。また、希望者の方にはお渡ししています。
- 「おもな検査項目の解説」 ⇒ NCH-FIG-00503おもな血液・尿検査結果の簡単な見方_Ver.6.202512.pdf (PDF 282KB)
血液や尿中の物質は、年齢・食物の摂取・運動・病気や身体の状態などいろいろな条件で変動します。当院では、症状の程度、治療の経過などを見る目的で血液や尿検査を行っています。基準値は大部分の人がこの範囲に入ることを意味します。しかし、必ずしも基準値だから良い、範囲外だから悪いというのではありません。測定の結果を自己流に判断せず、主治医の指導のもとでご活用下さい。
生化学・免疫検査室
生化学・免疫検査室では患者様の血液・尿などを検査材料として肝機能検査・腎機能検査・糖尿病関連検査・脂質検査・感染症検査・腫瘍マーカー検査・薬物検査などを測定しています。
当検査室では、自動分析機を使用する院内検査全項目について24時間測定しています。
また外来診察前に医師が検査結果を確認できるように、検査開始から1時間以内で検査結果を報告するように「迅速・正確」を目標に業務を行なっています。
各種自動分析機のメンテナンスを実施し正確で精度の高い検査報告が行えるよう努めており日本医師会、日本臨床衛生検査技師会、滋賀県臨床検査技師会が主催する精度管理事業に参加し良好な評価を得ています。

血液ガス測定機器
Rapidpoint500
ヘモグロビンA1C測定機器
HLCー723G11
生化学・免疫検査自動分析装置
cobas8000
血液検査室
私たちの体を流れる血液は、細胞成分である血球と、液体成分である血漿から成ります。
血液検査では、血球数や、血液細胞の形態を調べたり、血漿を用いて凝固・線溶検査を行っています。貧血・白血病など血液疾患の診断や治療効果、経過観察に必要な検査です。又、血液疾患だけでなく、感染症・悪性腫瘍・膠原病など多種多様な全身疾患のスクリーニング検査としても重要な検査です。
●血球計数検査
自動血球分析装置にて、血球計数(白血球数、赤血球数、血小板数など)を算定しています。
血球の量的異常や、貧血の程度などを調べます。
●血液像(白血球分画)検査
血球は、白血球・赤血球・血小板の3種類に分類され、さらに白血球は、好中球・好酸球・好塩基球・単球・リンパ球に分類されます。白血球分画も自動血球分析装置で測定をしていますが、必要と判断されたものについては、塗抹標本を作製し、血液細胞の形態を顕微鏡で観察します。
白血球は、ほぼ一定の割合でバランスをとっていますが、体に異常があるとそれらのバランスが崩れることがあります。細菌やウイルス感染などでは、好中球・単球・リンパ球が増減し、アレルギーなどでは、好酸球・好塩基球が増加します。又、血液疾患や薬剤、放射線の影響などでも増減します。
●骨髄像検査
血球成分の多くは、骨髄で造られています。
穿刺により、得られた骨髄液の細胞形態を顕微鏡で観察します。
血液細胞の成熟度、異常細胞の有無などを調べます。貧血や白血病などの血液疾患の診断や治療効果、癌の骨髄転移の有無などを調べる際に検査を行います。

●凝固・線溶系検査
血液凝固自動分析装置にて、止血・凝固に関わる成分や、凝固により形成されたフィブリンを溶解する線溶に関わる成分を測定しています。出血傾向や血栓傾向があるかがわかります。
経口抗凝固療法のモニタリングにも、この検査が利用されています。又、凝固因子の大部分が肝臓由来の為、肝機能の指標としても測定されています。
●血小板機能検査
血小板の異常には数の異常と機能の異常があります。
数の異常は、血球計数検査で調べていますが、これは血小板の質的異常をみる検査で、血小板の凝集反応をみています。
抗血小板薬のモニタリングにも利用されています。
●唾液分泌能検査
唾液の分泌量を評価する検査です。
サクソンテストを行っています。
一般検査室
一般検査室は、主に『尿検査』と『便検査』を行っています

| 尿検査 |
尿定性 尿沈渣 |
|---|---|
| 髄液検査 | 急性・慢性髄膜炎および髄膜症の診断、経過観察を行う検査 |
| 穿刺液検査 | 胸水、腹水、関節液、心嚢液等で疾病の診断や病態の判定に重要な検査 |
| 精液検査 | 不妊症の診断と治療の方向性を決定する検査 |
| 便検査 |
便潜血検査(免疫法)・・・大腸がんスクリ-ニング 虫卵検査 ロタウイルス検査 |
輸血検査室
輸血療法とは赤血球・血小板・凝固因子の機能や量が低下した時に、該当する血液成分を補充する治療法です。
輸血に使用する血液製剤は化学合成できる薬剤ではなく、献血による他人の血液であり大変貴重で有効性も高いものです。しかし、ごくまれに感染症や免疫反応などの副作用を起こす可能性があります。
そこで、当院輸血検査室では、日本輸血細胞治療学会認定輸血検査技師を含む3名の臨床検査技師が以下の項目を目的とし、安全かつ有効的に輸血が実施できるよう日々業務を行っています。
- 輸血事故の防止
- 輸血後感染症や輸血後副作用の監視
- 自己血製剤を含めた、輸血用血液製剤の一元管理
- 学会参加等による、輸血に関する情報の収集と院内への伝達
- 輸血療法委員会を通じて血液製剤の適正使用に努め、血液製剤廃棄があった場合の原因調査と改善
- 検査技師会精度管理事業への参加による輸血検査技術の向上と、迅速で正確な輸血関連検査の実施
業務内容
| 輸血検査業務 |
ABO式血液型検査 不規則抗体スクリーニング検査 不規則抗体同定検査 直接クームス検査 交差適合試験 不規則抗体価測定など |
|---|---|
| 輸血管理業務 | 輸血用血液製剤管理 自己血製剤管理 輸血用血液製剤管理台帳作成保管 血液製剤保冷庫管理(ICU、検査室) 輸血療法委員会事務局 院内輸血研修会の開催など |

全自動輸血検査機器IH-500を導入し
人為的な血液型入力ミスを防止しています。
細菌検査室
ヒトは通常、細菌・ウイルスなどの様々な微生物と共存して暮らしていますが、体内に強毒菌が侵入した時や、抵抗力がなくなった場合には均衡が崩れて感染症を引き起こします。
当院の細菌検査室では、そういった患者さんから出た検体(喀痰、尿、便、血液、膿、髄液、胸水、腹水、組織などあらゆるもの)を培養し、感染症の原因と思われる菌の菌種を同定し、その菌に効く薬剤は何かを調べております。
また、近年話題となっております薬剤耐性菌による院内感染を防止するため、医師・薬剤師・看護師などと連携を図りながら感染制御活動なども行っております。
塗抹検査
提出された検体を直接スライドグラスに塗布し、特殊な染色(グラム染色、チール・ネルゼン染色など)を施し、顕微鏡(1000倍)で観察します。染色性や菌の形態から起炎菌の推定を行います。
鏡検

黄色ブドウ球菌

結核菌
培養検査
提出された検体を、細菌が発育するのに必要な栄養素を含んだ寒天培地に接種し、ふらん器等で24時間培養します。1~2日培養を行うと培地上にコロニー(菌の塊)となって発育してきます。敗血症が疑われる時は、血液培養が行われます。抗酸菌の培養は、通常の微生物検査に比べ、菌の発育に長期間(3~8週間)要するのが特徴です。

培養操作

血液培養操作

ふらん器内の培地
同定・薬剤感受性検査
検体から培養された菌を用い、その菌の菌名が何なのか、どの薬剤に対して感受性があるのか(効くのか)を調べます。
培地に発育した菌
細菌自動分析装置
迅速検査
検体の提出から1時間以内に結果の分かる迅速検査を実施しております。
| 検査項目 | アデノウイルス、RSウイルス、A群β溶連菌抗原、尿中肺炎球菌抗原、尿中レジオネラ抗原、CDトキシン、ノロウイルス、マイコプラズマ抗原、水痘帯状疱疹ウィルス |
|---|
院内感染防止の活動
細菌検査室では、他部署に向け感染情報の発信をしております。当院で検出された細菌の種類や頻度などを統計処理し、データ解析を行い、そのデータをもとに医師、薬剤師、看護師と連携して、日々感染制御活動を行っております。
以上が細菌検査室の主な業務ですが、感染症の早期治療に少しでも貢献できるように努力いたします。また微生物検査の結果は、材料の採り方や保管の仕方によって、大きく左右されます。患者さまのご協力をお願いいたします。
病理検査室

病理検査とは
病気の診断を行うために患者さんから採取した臓器・組織・細胞などを肉眼や顕微鏡で詳しく調べることです。
病理検査には以下の方法があります。
- 細胞診検査
- 病理組織検査
- 術中迅速検査
- 病理解剖
1 細胞診検査
身体より得られた細胞を調べる検査です。材料には体腔液(胸水、腹水など)や尿、喀痰などがあり、スライドガラスに薄く塗りつけて染色(細胞に色をつけます)します。 染色標本を顕微鏡で観察し、悪性(がん)細胞の有無などを検査します。比較的患者さんの負担が少ないことが特徴です。
細胞検査士がスクリーニング(顕微鏡による観察)を行い、異常な細胞やチェックすべき細胞があった標本は病理医(細胞診指導医)と検討し、その細胞所見や推定病変を報告しています。
2018年4月に日本臨床細胞学会施設認定を取得しました。

婦人科擦過標本

HPV感染細胞
2 病理組織検査
内視鏡や手術により取り出された臓器・組織を調べる検査です。肉眼や顕微鏡で観察し、病気の種類や原因などについて病理医が診断を行います。
(生検)
内視鏡や気管支鏡を行った際に病変の一部を摘み取ったり、皮膚などにできたできものの一部をメスで切り取ったりして標本にします。病気の種類を確定診断する検査で、その後の治療方針を決める重要な検査です。
(手術で摘出された臓器・組織の診断)
病気の種類についてさらに詳しい検査を行います。病変の大きさや広がり、完全に取りきれているかなどを観察します。がんの場合は悪性度や転移の有無などを調べます。この検査で診断が確定し、術後の治療方針決定に役立ちます。
顕微鏡標本の作製は臨床検査技師が行っています。組織を厚さ3マイクロメートル(1mmの3/1000)程度に薄く切ってスライドガラスに貼り付け、染色(細胞に色をつけます)し標本を作製します。通常のHE(ヘマトキシリン・エオジン)染色のほかに、特殊染色や免疫染色も行っています。

大腸HE標本
3 術中迅速検査
手術中に採取された検体を提出から30分程度で病理診断・細胞診断を行います。
手術前に病理診断がつかなかった病変について悪性(がん)か否か、病変がとりきれているかどうかの確認や手術で切除する範囲を決めたりするのに役立ちます。
4 病理解剖
ご遺族の承諾のもとに、病死された患者さんを解剖させていただくことです。
病気がどのようなものであったか、治療効果や死因の究明をし、今後の治療と診断に役立たせていただいています。
生理機能検査室
1.心電図室
2階心電図室では、通常の心電図検査だけでなく様々な検査を行っています。今回は代表的な3つの検査について解説します。
●心電図検査(安静時・マスター運動負荷・ホルター心電図)
心電図検査は、心臓全体のはたらきを調べることができ、心臓病の発見や診断、病状の把握、治療効果の確認、薬の副作用の発見などに欠かせない検査です。通常、両手首と両足首、胸に6ヶ所電極を付けて検査を行います。心臓の拍動に伴っておこるわずかな電位変動を記録していくもので、体に電流が流れることはなく、苦痛を伴う検査ではありません。検査時間も通常は3~5分で終了します。
必要に応じて、運動をして心臓に負荷をかけるマスター運動負荷心電図検査や、24時間通常の生活時の心電図を記録するホルター心電図検査も行っています。



●心機図(ABI)検査
ABI検査とは手と足の血圧の比較や脈波の伝わり方を調べることで、動脈硬化の程度を数値として表したもので、この検査を行うことにより動脈硬化(血管の老化など)の度合や早期血管障害を検出することができます。ベッドの上で仰向けになり、両側の腕と足首に血圧計の帯(カフ)を、両手に心電図の電極、胸部に心音マイクを装着し検査を行います。検査時間はおよそ5分程度です。

●肺機能検査
肺の病気の診断、重症度などを調べるのに役立ち、治療効果の測定にも使われています。気管支喘息の診断にも重要な検査で、手術のときの麻酔法の選択の時にも利用されています。鼻をノーズクリップで止め、呼吸管を接続したマウスピースを口にくわえた状態で検査を行います。通常は、静かな呼吸を数回繰り返した後、一度大きく息を吐き(最大呼気)、次に大きく息を吸い(最大吸気)、さらに大きく息を吐く肺活量と静かな呼吸を2~3回繰り返したのち、大きく息を吸い、一気に強い息を全部吐く努力性肺活量および1秒量の測定を行います。検査は10分くらいで終了し、苦痛は全くありませんが、患者様の努力と協力が必要になる検査です。必要に応じてさらに詳しい肺機能をみる二次検査も行っています。
2.2階エコー検査室
2階のエコー検査室は3部屋あります。どちらの部屋も同じ検査を行っています。ここでは心臓・頚動脈・下肢動静脈の超音波検査を行っています。超音波検査(エコー検査)とは、人の耳には聞こえないほどの高周波数の超音波を心臓に発信して、返ってくるエコー(反射波)を受信し、心臓の様子を画像に映し出して診断する検査です。X線撮影やRI検査のように放射線による被曝の心配がありませんので、妊婦や乳幼児でも安心して受けることができる検査です。30分~1時間の予約検査ですので、検査を受けられる方はお時間に遅れないように5~10分前にはエコー検査室にお越しください。
●心臓超音波検査(心エコー検査)
心臓超音波検査を行う目的は大きく分けて2つあり、1つは心臓の形の異常を発見する形態的診断、もう1つは心臓の働きを見る機能的診断です。心臓は常に拍動していますので、その動いている状態をそのまま観察できる、とても有用な検査といえます。心室や心房の大きさや壁の厚さ、壁の動き、弁の形態や動きはもちろん、カラードップラー法を行なうと、心臓の中の血液の流れを映し出すことができ、弁の異常や壁に穴があいているかどうかなどの異常を発見できます。さらにPW法、CW法などの方法で、心臓の圧も推定できます。胸部を露出した状態で左側臥位になってもらい、プローブと呼ばれる超音波発信機を肋骨の隙間に沿うようにあてて行います。プローブと皮膚の間に隙間が開かないようにゼリー剤を使用してピッタリと密着させて行います。検査時間は20~30分程度です。
●頚動脈超音波検査(頚動脈エコー検査)
主に頚動脈の動脈硬化を調べる検査です。頚部にプローブをあてて検査します。血管壁内の状態、血管表面の状態、血管内腔の状態を見ることができ、動脈硬化を視覚的にとらえ診断することができます。頚部は、心臓から脳あるいは脳から心臓へと巡る血管の通り道です。もしその通り道が狭くなったり、血液中に血のかたまり(血栓)などが混じっていたりすると、脳や心臓の血管を詰まらせる危険性があります。高血圧や高脂血症、糖尿病、肥満を有する人や、その境界値にいると考えられる人に対して、脳および心臓疾患の発症予防や動脈硬化判定に有用とされています。
●下肢静脈超音波検査(下肢静脈エコー検査)
エコノミークラス症候群に代表される深部静脈血栓症(DVT)の診断に用いられる検査です。DVTによる肺塞栓症が近年増加傾向にあり、整形外科手術の術後に発症するケースも数多く報告されています。造影剤を使用しない非侵襲性の検査で安全・安価な検査としてDVT診断に多く用いられています。下半身を下着のみの着用で露出し、基本は仰臥位で、両足の付け根の部分から足先までプローブをあてて検査します。下肢静脈エコー検査において、各静脈の圧迫による虚脱の有無が最も重要であり、次に静脈径の拡張やモヤモヤエコー、血栓の有無を調べます。
●下肢動脈超音波検査(下肢動脈エコー検査)
閉塞性動脈硬化症(ASO)の診断に用いられる検査です。その他、急性動脈閉塞、膝窩動脈外膜嚢腫、仮性動脈瘤などの診断にも有用です。また、ステント留置後の経過観察にも威力を発揮します。基本的には仰臥位で、両足の付け根の部分から足先までプローブをあてて検査します。ABIなどと合わせて評価を行います。
●腹部超音波検査(腹部エコー検査)
ベッドに仰向けになり腹部に超音波をあて、腹部臓器の状態を調べる検査です。主に肝臓・胆嚢・膵臓・脾臓・腎臓の大きさや形状、血流について観察することが目的です。各臓器の腫瘍や炎症の有無、胆石、ポリープ、嚢胞などの限局性病変や脂肪肝、慢性肝炎などのびまん性疾患などを観察する検査です。結石や脂肪肝など生活習慣病と関連が強い所見も発見できる検査です。
●腎動脈超音波検査(腎動脈エコー検査)
ベッドに仰向けになり上腹部に超音波をあて、腎臓と腎動脈の状態を調べる検査です。主に動脈硬化などによる腎動脈狭窄の有無について確認することが目的です。腎臓は心臓から送り出される血液中の老廃物を濾過し、尿に変えて体外に排出することや血圧を調整するなど様々な働きをしています。腎臓に流れる血管=腎動脈に狭窄や閉鎖が起こると腎臓の機能が低下して体内の老廃物を排出できなくなり、全身のむくみ、血圧上昇、呼吸困難といった症状が現れます。特に高血圧のある方の一割程度にみられる腎動脈狭窄の検出にこの検査が有用とされています。
3.脳波・神経生理検査室
脳波・神経生理検査室では2つのシールドルーム(電気的に隔離された部屋)で脳波検査、神経伝導速度検査、体性感覚誘発電位、聴性脳幹反応、視覚誘発電位の検査を行っています。
●脳波検査
脳はその活動にともなって常に微弱な電波を出し続けており、それは頭の表皮上におけるわずかな電位差(電流は電位の高いほうから低いほうへ流れる)となってあらわれます。その電気的な変動を頭部に付けた電極でとらえ、増幅し、波形として記録するのが脳波検査です。けいれんを起こしたとき、意識障害がみられるとき、症状には出ない軽い意識障害をみつけようとするとき、てんかんが疑われるときなどに行われ、脳腫瘍などの診断にも有用です。脳死判定の際にも用いられています。ベッドに仰向けに寝て、頭に十数個の電極をペースト(糊)で取り付けます。安静にしていて、目を開いたとき、目を閉じたとき、深呼吸をしたときなどの脳波を調べます。てんかんなどでは光や音の刺激を与えたときの脳波を調べたり、睡眠中の脳波を測定することもあります。

●視覚誘発電位検査
脳の後頭部付近に「見えた」と最終判断を下す視覚領があり、その視覚領からの電気反応のことを視覚誘発電位といいます。点滅している光や、白黒反転する市松模様などを見せた場合、正常に見えていれば、ある一定の電位変化を示します。白内障の手術の前など眼球内の網膜や硝子体の状態を見た後にその先がどうなっているかを調べるために行われることがあります。視覚誘発電位は、直径1cmの銀板皿状の電極を、毛髪の上から後頭部に貼り付けます。検査は片目ずつ行い、座った姿勢で点滅する光や市松模様を2~3分見つめます。その間に、光の刺激によって誘発される小さな電位変化が、脳波の中に発生します。それを特殊なコンピュータで処理して、視覚誘発電位のみを抽出記録します。この電位が記録されないということは、視神経をはじめ脳の中に病変があることを示唆しますから、白内障の手術をしても、視力の上昇は期待できないといえます。
●聴性脳幹反応検査
ABR検査(聴性脳幹反応)とは、乳幼児や高齢者など、音が聞こえたかどうかを返事できない人に行なう聴力検査(他覚的聴力検査)のことです。また、感音性難聴であることがわかったときに、障害の場所を明らかにするためにも行なわれます。その他、手術時に生じる脳幹の機能異常を調べたり、最近では脳死の判定にも使われています。この検査では内耳(蝸牛)から脳までの、聴神経の伝達経路のどこに異常があるかを調べることができます。ベッドに横になり、左右の耳たぶと頭部(頭頂部と前額部)の計4ヶ所に脳波形の電極を取り付けます。ヘッドホンから音が聞こえると、脳が反応して脳波に変化が生じるため、その波形をコンピュータ処理して画面にあらわします。検査中は体を動かさないようし、乳幼児では睡眠薬で眠らせてから検査を行なうこともあります。
4.心肺運動負荷試験(CPX検査)
心肺運動負荷試験(CPX)とは、呼気ガス分析を併用して運動に対する肺・心血管系・骨格筋を含めた予備能力(運動耐容能)を測定する検査です。 具体的には、心電図・血圧・呼吸中の酸素・二酸化炭素の濃度を計測しながらエルゴメータ(自転車こぎ)を行います。
運動耐容能は、以下の3つの因子によって決定されます。
- 肺がどれだけの酸素を血液中に取り込めるか。
- 心血管系がその血液をどれだけ運動筋に送り出せるか。
- 運動筋がその血液からどれだけの酸素を取り込み、それによってどれだけのエネルギーを産生できるか。
つまり、心肺運動負荷試験はあらゆる心肺疾患患者が検査対象となります。
| 検査を行う目的 | 運動療法への適応と運動処方の作成 運動療法、薬物療法、外科的治療などの効果判定 心肺疾患患者への日常生活指導の指針 心肺疾患の重症度の定量的評価 潜在的心肺疾患の検出とその重症度評価 |
|---|

ここでご紹介している検査を受けるには、主治医の指示が必要です。
気になる症状がある方は主治医の先生と相談の上、検査にお越しください。スタッフ一同、笑顔でお迎えいたします。
学会・論文発表
論文発表(令和元年度)
西野万由美、宮元伸篤、古賀一也、岡本明子、新川由基、黒澤学、沢田眞治
唾液腺多形腺腫由来癌の1例
滋賀医学検査Vol.10 No.1 通巻10号(2020年3月)
学会・研究発表(令和6年度)
山村有希、源宜彦、北川文香、岩嵜早織、饗場美玲、磯嶋昭子、西尾良子
アブレーション治療後の医原性心房中隔欠損の残存により心不全をきたした一例
第47回滋賀県医学検査学会 令和7年2月23日(長浜バイオ大学)
宮元伸篤、岡本明子、西野万由美、古賀一也、黒澤学
尿細胞診標本作製の技術向上を目指して
第60回滋賀県臨床細胞学会学術集会 令和7年3月15日(滋賀県立総合病院)
学会・研究発表(令和5年度)
宮元伸篤
就業規定が変わったら時間外勤務は減るのか?
第20回日本医療マネジメント学会京滋支部学術集会 令和5年10月28日(長浜文化芸術会館)
宮元伸篤、岡本明子、西野万由美、古賀一也、新川由基、黒澤学
長期経過のCLL/SLLを経験して
第59回滋賀県臨床細胞学会学術集会 令和6年1月27日(滋賀医科大学)
山村有希
心電図検査と超音波検査
第3回滋賀県診療放射線技師会学術研修会 令和6年1月28日(コラボ滋賀21)
古賀一也、岡本明子、西野万由美、服部はづき、宮元伸篤、黒澤学
当院におけるASC判定の検討
第46回滋賀県医学検査学会 令和6年2月25日(クサツエストピアホテル)
学会・研究発表(令和4年度)
宮元伸篤
自動染色装置を使用したビクトリア青-HE染色について
2022年度日臨技近畿支部病理細胞診研修会 令和4年12月17日(Web)


